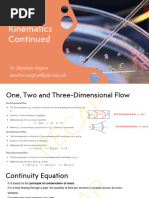

0% found this document useful (0 votes)
145 views10 pagesTypes of Fluid Motion Explained
The document discusses four types of motion:
1) Linear translation, where fluid elements move bodily from one position to another parallel to the original position.
2) Linear deformation, where the axis of the deformed fluid element is parallel but different in length to the original.
3) Angular or shear deformation, defined as the average change in angle between adjacent sides.
4) Rotation, where both axes of the fluid element rotate in the same direction.
Uploaded by
Hitesh MudgilCopyright
© © All Rights Reserved
We take content rights seriously. If you suspect this is your content, claim it here.
Available Formats
Download as PPTX, PDF, TXT or read online on Scribd
Topics covered
- Conservation of Momentum,
- Fluid Mechanics,
- Axes Movement,
- Mechanical Properties of Fluid…,
- Flow Rate Consistency,
- Fluid Dynamics,
- Shear Strain Rate,
- Linear Deformation,
- Boundary Layer Theory,
- Rate of Flow
0% found this document useful (0 votes)
145 views10 pagesTypes of Fluid Motion Explained
The document discusses four types of motion:
1) Linear translation, where fluid elements move bodily from one position to another parallel to the original position.
2) Linear deformation, where the axis of the deformed fluid element is parallel but different in length to the original.
3) Angular or shear deformation, defined as the average change in angle between adjacent sides.
4) Rotation, where both axes of the fluid element rotate in the same direction.
Uploaded by
Hitesh MudgilCopyright
© © All Rights Reserved
We take content rights seriously. If you suspect this is your content, claim it here.
Available Formats
Download as PPTX, PDF, TXT or read online on Scribd
Topics covered
- Conservation of Momentum,
- Fluid Mechanics,
- Axes Movement,
- Mechanical Properties of Fluid…,
- Flow Rate Consistency,
- Fluid Dynamics,
- Shear Strain Rate,
- Linear Deformation,
- Boundary Layer Theory,
- Rate of Flow